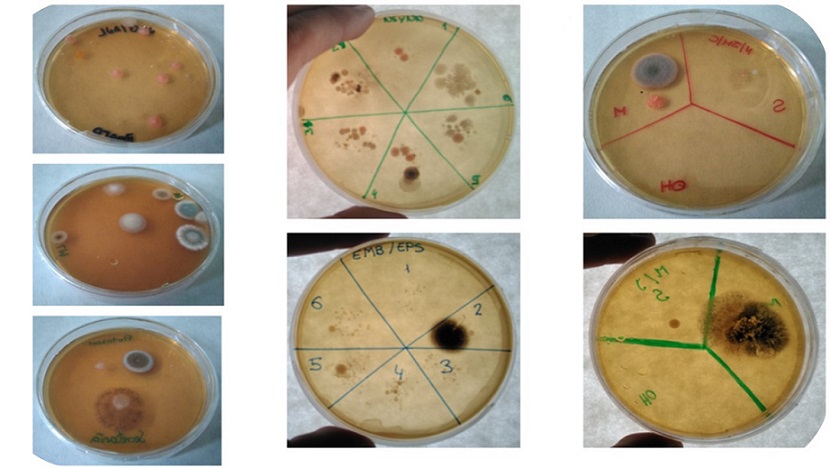

Formando a futuros maestros para abordar los microorganismos mediante actividades prácticas. Papel de las emociones y valoraciones de los estudiantes
DOI
https://doi.org/10.25267/Rev_Eureka_ensen_divulg_cienc.2019.v16.i1.1602Información
Resumen
Resumen: Para promover la motivación y el aprendizaje sobre los microorganismos se ha recomendado implementar actividades prácticas. Sin embargo, los docentes realizan pocas prácticas de Microbiología, área en la que, al igual que sus alumnos, presentan ideas alternativas. Dada esta situación, es necesario formar a los futuros docentes en la enseñanza de los microorganismos. En el presente trabajo se describe una práctica para la enseñanza de conceptos microbiológicos básicos a maestros en formación inicial, así como los resultados de su implementación en el aprendizaje y las emociones de los participantes. Los resultados muestran que dicha práctica es efectiva, motivante y bien valorada por los participantes en relación a su futuro profesional; observándose correlaciones entre estos aspectos. En concreto, se han detectado asociaciones positivas entre las emociones positivas y los resultados de aprendizaje, y entre estos y el valor otorgado a la práctica; así como una asociación negativa entre las emociones negativas y los resultados de aprendizaje.
Palabras clave: Microbiología, Educación Primaria, enseñanza práctica, formación inicial, emociones
Training future Primary teachers to approach microorganisms through practical activities. Role of students´ emotions and values
Abstract: In order to foster motivation and learning about microorganisms, the implementation of practical activities has been recommended. However, Primary teachers rarely perform Microbiology practices, a branch of science in which they hold some misconceptions, like their students. To reverse this situation, it is necessary to develop the ability to teach these practices in prospective teachers. In this contribution we describe a practice to teach basic microbiological concepts to prospective Primary teachers, as well as the effect of its implementation in students learning outcomes and their emotions. Results show that the practice is effective, motivating and well-valued by participants in relation to their professional future, observing correlations between these aspects. In particular, positive associations between positive emotions and learning outcomes are detected, and between these and value towards practice; as well as negative association between negative emotions and learning outcomes.
Keywords: Microbiology, Primary Education, practical teaching, teacher training, emotions
Descargas
Agencias de apoyo
Cómo citar
Licencia
Derechos de autor 2018 Los/as autores/as pueden mantener el copyright, concediendo a la revista el derecho de primera publicación. Alternativamente, las/os autoras/es puede transferir el copyright a la revista, la cual permitirá a las/os autoras/es el uso no-comercial del trabajo, incluyendo el derecho a colocarlo en un archivo de acceso libre. Además, se puede consultar Creative Commons sobre licencias de copyright flexibles.

Esta obra está bajo una licencia internacional Creative Commons Atribución-NoComercial-SinDerivadas 4.0.
Aquellos autores/as que tengan publicaciones con esta revista, aceptan los términos siguientes:
- Los autores/as podrán conservar sus derechos de autor y garantizarán a la revista el derecho de primera publicación de su obra, el cual estará simultáneamente sujeto a la Licencia de reconocimiento de Creative Commons que permite a terceros compartir la obra siempre que se indique su autor y su primera publicación esta revista.
- Los autores/as podrán adoptar otros acuerdos de licencia no exclusiva de distribución de la versión de la obra publicada (p. ej.: depositarla en un archivo telemático institucional) siempre que se indique la publicación inicial en esta revista.
- Se permite y recomienda a los autores/as difundir su obra a través de Internet (p. ej.: en archivos telemáticos institucionales o en su página web) una vez el manuscrito sea aceptado, lo cual puede producir intercambios interesantes y aumentar las citas de la obra publicada. (Véase El efecto del acceso abierto). También se permite la difusión de la versión pre-print de los artículos a partir del momento en que son aceptados o publicados
Reconocimiento-NoComercial
CC BY-NC
Citas
Ballesteros M. I., Paños E., Ruiz J. R. (2018) Los microorganismos en la educación primaria: ideas de los alumnos de 8 a 11 años e influencia de los libros de texto. Enseñanza de las ciencias 36(1), 79-98
Carrascosa J. (2005) El problema de las concepciones alternativas en la actualidad (parte I). Análisis sobre las causas que la originan y/o mantienen. Revista Eureka sobre Enseñanza y Divulgación de las Ciencias 2(2), 183-20
Damasio A. (2010) Y el cerebro creó al hombre. Barcelona: Destino
Dunsmoor J., Murty V., Davachi L., Phelps E. (2015) Emotional learning selectively and retroactively strengthens memories for related events. Nature 520, 345–348
Edelson M., Sharot T., Dolan R., Dudai Y. (2011) Following the crowd: brain substrates of long-term memory conformity. Science 333(6038), 108-111
Faccio E., Costa N., Losasso C., Cappa V., Mantovani C., Cibin V., Andrighetto I., Ricci A. (2013) What programs work to promote health for children? Exploring beliefs on microorganisms and on food safety control behavior in primary schools. Food Control 33(2), 320-329
Frenzel A., Goetz T., Lüdtke O., Pekrun R., Sutton R. (2009) Emotional transmission in the classroom: exploring the relationship between teacher and student enjoyment. Journal of educational psychology 101(3), 705-716
Gormally C., Brickman, P., Hallar B., Armstrong N. (2009) Effects of inquiry-based learning on students’ science literacy skills and confidence. International journal for the scholarship of teaching and learning 3(2), 16-22
Harms U. (2002) Biotechnology education in schools. Electronic Journal of Biotechnology 5(3), 5-6
Hofstein A., Lunetta V. (2004) The laboratory in science education: Foundations for the twenty‐first century. Science education 88(1), 28-54
Hulleman C., Harackiewicz J. (2009) Promoting interest and performance in high school science classes. Science 326 (5958), 1410-1412
Jones M., Rua M. (2006) Conceptions of germs: Expert to novice understandings of microorganisms. Electronic Journal of Science Education 10(3), 1-40
Karadon H. D., Şahin N. (2010) Primary school students’ basic knowledge, opinions and risk perceptions about microorganisms. Procedia-Social and Behavioral Sciences 2(2), 4398-4401
Kensinger E., Corkin S. (2004) Two routes to emotional memory: Distinct neural processes for valence and arousal. Proceedings of the National Academy of Sciences of the United States of America 101(9), 3310-3315
Marcos-Merino J. M., Esteban R. (2018). Concepciones alternativas sobre Biología Celular y Microbiología de los maestros en formación: implicaciones de su presencia. Campo Abierto 6(2), 167-179
Marcos-Merino J. M., Esteban R., Gómez J. (2016). Efecto de una práctica docente diseñada partiendo de las emociones de maestros en formación bajo el enfoque Ciencia, Tecnología y Sociedad. Indagatio didactica 8(1), 143-157
Mellado V., Borrachero A., Dávila M., Melo L., Brígido M. (2014) Las emociones en la enseñanza de las ciencias. Enseñanza de las ciencias 32, 11-36
Pekrun, R. (2014) Emotions and learning. Ginebra: International Academy of Education/International Bureau of Education.
Pekrun R., Goetz T., Frenzel A., Barchfeld P., Perry R. (2011) Measuring emotions in students’ learning and performance: The Achievement Emotions Questionnaire (AEQ). Contemporary educational psychology 36(1), 36-48
Redfern J., Burdass D., Verran J. (2013) Practical microbiology in schools: a survey of UK teachers. Trends in microbiology 21(11), 557-559
Retana D. A., De las Heras-Pérez M. Á., Vázquez-Bernal B., Jiménez-Pérez R. (2018) El cambio en las emociones de maestros en formación inicial hacia el clima de aula en una intervención basada en investigación escolar. Revista Eureka sobre Enseñanza y Divulgación de las Ciencias 15(2), 1-16
Simonneaux L. (2000) A study of pupils’ conceptions and reasoning in connection with ’microbes’, as a contribution to research in biotechnology education. International Journal of Science Education 22(6), 619–644
Smith M., Wood W., Knight J. (2008). The genetics concept assessment: a new concept inventory for gauging student understanding of genetics. CBE- Life sciences Education 7(4), 422-430
Vicente M., Garcia-Ovalle M., Medina J. (2010) Ni contigo ni sin ti (Guía para entender los microbios). Madrid: Ediciones Grand Guignol





